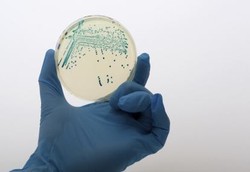
Bakteri Kebal Antibiotik Ditemukan di Gua Berumur 4 Juta Tahun

detikFinance
Dahlan Iskan: Garuda yang Kalahkan MAS dan BatanTek yang Mengasia
Dua lagi perusahaan BUMN yang tahun ini melejit melampaui batas negara: PT Garuda Indonesia (Persero) Tbk dan PT Batan Teknologi (Persero).
Senin, 11 Jun 2012 08:04 WIB